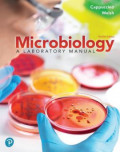
cover

✨ 10 results found - Searched 23331 records in 4ms.

Buku
Pedoman Biorisiko Laboratorium Institusi "Institution Biorisk Laboratory Manual"
2019 | BY Ida Susanti- Nomor Panggil QY 26 I18 2019

e-Books
Anatomy & physiology laboratory manual: ELI NAS 161 & ELI NAS 162
2016 | BY Bawa, Raj- Nomor Panggil QT 29 B354 2016
e-Books
Benson's Microbiological Applications : Laboratory Manual in General Microbiology 14th Edition
2015 | BY Heidi R. Smith - Alfred E. Brown- Nomor Panggil QW 25 AL392 2015
e-Books
WHO Laboratory Manual for the Diagnosis of Diphtheria and Other Related Infections
2021 | BY WORLD HEALTH ORGANIZATION (WHO)- Nomor Panggil QW 23 W927 2021
e-Books
Microbiology a Laboratory Manual
2020 | BY Welsh, Chad - James G. Cappuccino, Emeritus- Nomor Panggil QW 25 J27 2020

Buku
Nutritional assessment : a laboratory manual / Rosalind S. Gibson
1993 | BY GIBSON, Rosalind S.- Nomor Panggil QU 146 G448n 1993

Buku
Kinesiology laboratory manual for physical therapist assistants
1998 | BY Minor, Mary AD - Lippert, Lynn S.- Nomor Panggil WE 23 M666k 1998
e-Books
Immunology & Seralogy in Laboratory Medicine
2014 | BY Mary Louise Turgeon- Nomor Panggil QW 525 T936 2014
e-Books
Andrological Evaluation of Male Infertility : A Laboratory Guide
2016 | BY Rakesh Sharma - Sajal Gupta - Ashok Agarwal- Nomor Panggil WJ 25 AG261 2016
e-Books
Parasite Genomics Protocols 2nd Edition
2015 | BY Christopher Peacock- Nomor Panggil QX 25 C556 2015
